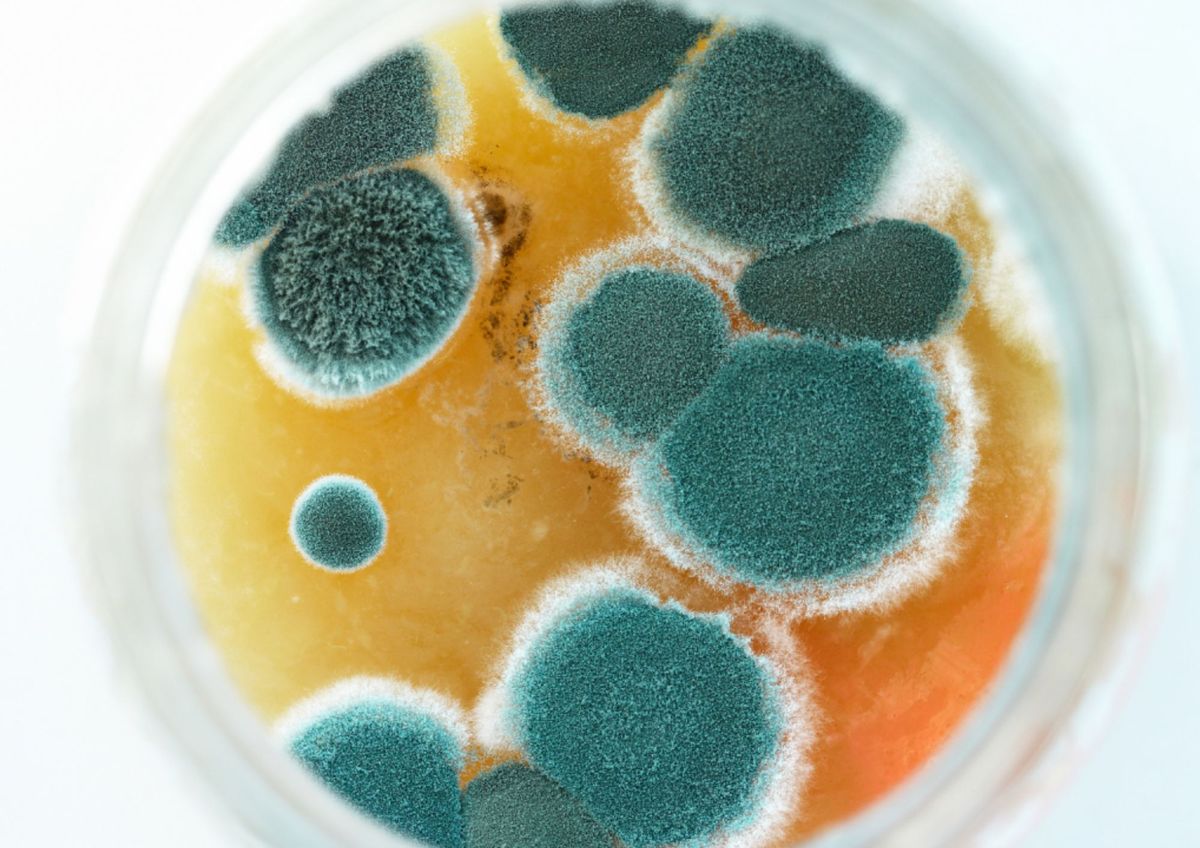

La calidad y buen estado de los alimentos es importante para garantizar el bienestar y la salud en general. Consumir productos contaminados por patógenos como hongos y bacterias puede ocasionar daño o infecciones de transmisión alimentaria. Una de las costumbres más frecuentes y repetidas es la de cortar las partes con moho de los alimentos contaminados y comer el resto, sin rastros aún de hongo.
La ciencia detrás del moho: cómo llegan a los alimentos, de qué manera se reproducen y qué tan tóxicos son
El moho es un hongo presente en los espacios exteriores e interiores. Estos organismos tienen la capacidad de contaminar y colonizar alimentos. Lo hay de distintas especies y variedades más o menos afines a ciertos alimentos, con distintos requisitos de proliferación y diversos grados de toxicidad. Su aparición y colonización deteriora los alimentos volviendolos no aptos ni seguros para el consumo.
Los mohos están en el aire, las superficies y la tierra. Son organismos que prefieren ambientes cálidos, húmedos y ricos en nutrientes, según lo explicado por la investigadora Elisabetta Lambertini. Es importante refrigerar los alimentos y cerrarlos herméticamente para evitar el desarrollo de microorganismos.
Los hongos se reproducen y propagan mediante esporas, mecanismo que facilita su transporte a los alimentos por medio del aire o agua. Aunque no todo el moho es tóxico, es muy difícil determinar cuál sí y cuál no, por ello especialistas de seguridad alimentaria recomiendan no consumir estos productos.
Existen casos en los cuales el hongo es el elemento principal e intencional del alimento, como es el caso del queso azul. Es importante identificar el moho y actuar de inmediato.
Fin del misterio: ¿es posible cortar la parte con moho de los alimentos y consumir el resto aún sin hongos?
No, no es recomendable cortar la parte con moho y comer el resto. Si bien sólo una parte de los alimentos puede parecer contaminada, el resto también lo está aunque no sea visible. En cuando se observan puntos negros o verdes en el pan, queso, yogures, frutos secos, frutas y verduras, hay que desecharlos inmediatamente.
Algunos tipos de hongos generan micotoxinas en los alimentos. Las micotoxinas son sustancias muy tóxicas para el organismo que se desarrollan en condiciones de humedad y temperatura óptimas. Además de deteriorar los alimentos, este tipo de moho facilita la transmisión de infecciones alimentarias. Algunas de ellas son:
- Aflatoxinas: son micotoxinas presentes en alimentos como el maíz, los frutos secos y lácteos.
- Fumonisinas: son micotoxinas generadas por el moho presente en cereales y algunas carnes como el cerdo.
- Tricotecenos: las personas que ingieren esta toxina pueden experimentar náuseas, vómitos, diarreas, dolor abdominal y mareos.